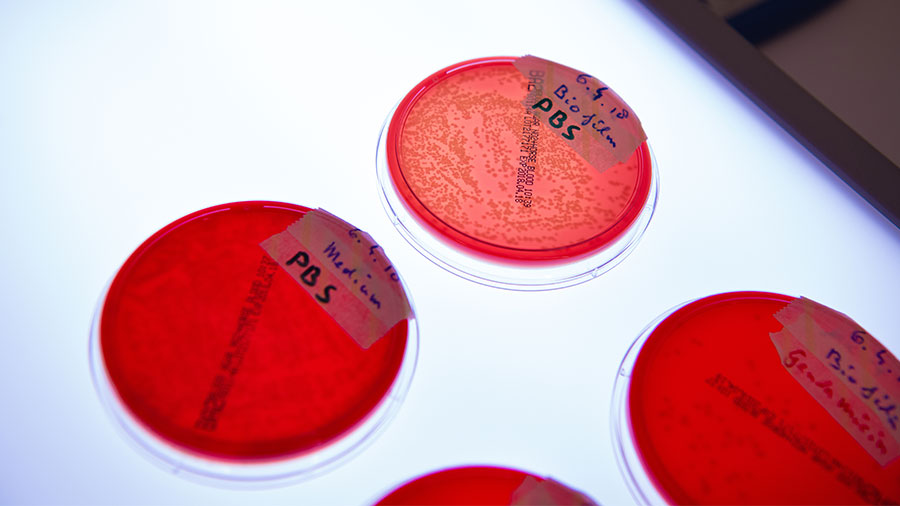

Infection Biology

Fracture-related infection (FRI) remains one of the most challenging complications in orthopedic and musculoskeletal trauma surgery. FRI has been convincingly shown to delay healing, worsen functional outcome, and incur significant socio-economic costs. Antibiotic prophylaxis, wound debridement, and postsurgical care can reduce, but not prevent, the incidence of these infections and so novel interventional strategies are required. The infection biology team work on in vitro, in vivo and ex vivo studies to better understand, diagnose, prevent and treat FRI.
In order to address the specific challenges of FRI, it is important to understand not only the host-pathogen interaction, but also the role the injury and the surgical fixation have on the risk of infection, and where novel interventional strategies may be applied in clinical routine. One in-house development, in collaboration with the Biomedical Materials focus area, is an antibiotic-loaded thermo-responsive hyaluronic acid-based hydrogel. By developing a flowing delivery vehicle, we can apply antibiotic throughout even the most complex wounds regardless of fracture type or fixation method. Anti-biofilm activity was confirmed in vitro, and efficacy has been proven in both prophylactic and therapeutic preclinical in vivo models.
In collaboration with the Preclinical Services program, we have also focused on the development of standardized in vivo models of FRI that may be used to test the performance of any such new intervention. This includes models with functional fracture fixation devices in a range of small and large animal species and including antibiotic resistant pathogens. Although direct extrapolation from preclinical studies to the clinical setting is difficult, the development of models that more closely recapitulate FRI is expected to increase the relevance and comparability of results arising from preclinical studies. Our laboratory also has experience in working on GLP studies of infection evaluating performance of novel antimicrobial interventions with a view towards translation to the clinic.
Our goal is
To develop and test novel anti-infective interventions targeting the clinical challenge of musculoskeletal infection.